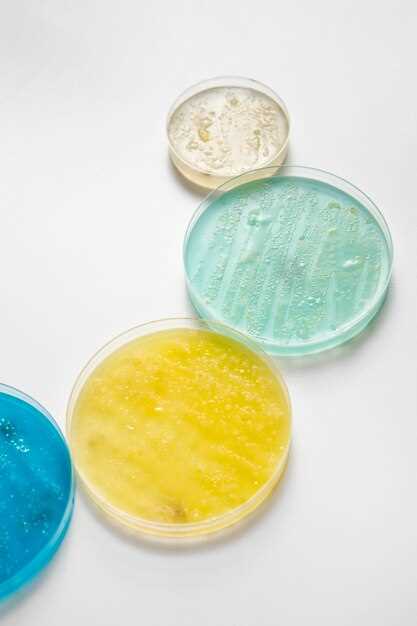
Step 3: Monitoring

Clonidine patch in neonates
2026-02-10Clonidine patch offers a safe and effective solution for managing symptoms in neonates. With its innovative design and gentle application, this patch provides continuous relief without the need for frequent dosing. Trust in the power of clonidine to help your little one stay comfortable and calm. Discover the benefits today.
Benefits for Neonates
Clonidine patch is a valuable treatment option for neonates with various medical conditions. The benefits of using the Clonidine patch in neonates include:
1. Effective Management of Hypertension
Clonidine patch has been shown to effectively control blood pressure in neonates with hypertension, helping to reduce the risk of related complications.
2. Improved Neonatal Abstinence Syndrome (NAS) Symptoms
For neonates experiencing withdrawal symptoms due to opioids or other substances, Clonidine patch can help alleviate these symptoms and improve the comfort of the neonate.
Overall, the Clonidine patch offers a safe and effective way to manage various medical conditions in neonates, providing relief and improving overall health outcomes.
Benefits for Neonates
Clonidine patch offers significant benefits for neonates in managing various conditions. Some key advantages include:
- Effective control of blood pressure in premature infants
- Reduction of agitation and restlessness in newborns
- Improved sleep patterns and regulation in neonates
- Enhanced comfort and calmness during medical procedures
By using the Clonidine patch according to the recommended guidelines, healthcare providers can help optimize the care and well-being of neonates in critical medical situations.
Usage Guidelines

Proper application of the Clonidine Patch is crucial for the effective treatment of neonates. Follow these guidelines to ensure its correct use:
Step 1: Preparation
Before applying the patch, clean and dry the skin where it will be placed. Avoid areas with cuts, irritation, or hairy skin.
Step 2: Application
Peel off the protective liner from the patch and carefully apply it to the designated area. Press firmly to ensure adhesion.
Important: Do not cut the patch or cover it with anything else, such as plastic wrap.
Step 3: Monitoring
Keep a close eye on the patch and the skin underneath for any signs of irritation, redness, or allergic reactions. Contact healthcare if any issues arise.
Reminder: Do not remove the patch unless directed by a healthcare professional.
Proper Application Techniques
Correct application of the Clonidine patch is crucial to ensure its effectiveness and safety in neonates. Follow these steps carefully to apply the patch correctly:
Step 1: Prepare the Skin
Clean and dry the skin where you will be applying the patch. Make sure there are no cuts, rashes, or irritation on the skin.
Step 2: Remove Protective Liner
Gently peel off the protective liner from the patch, taking care not to touch the adhesive side with your fingers.
Step 3: Apply the Patch
Place the adhesive side of the patch directly onto the clean, dry skin. Press down firmly to ensure good contact with the skin.
Step 4: Secure the Patch
Smooth out any wrinkles or air bubbles under the patch. Make sure the edges are well adhered to the skin.
Step 5: Dispose of the Used Patch
After wearing the patch for the recommended time, remove it carefully and dispose of it properly according to the instructions provided.
| Warning: Do not cut the patch to adjust the size, as this may affect the dose and lead to improper absorption. |
By following these proper application techniques, you can ensure that the Clonidine patch delivers the intended dose effectively and safely to the neonate.
Monitoring and Adjustment
Proper monitoring of the patient's response to the Clonidine patch is crucial for ensuring its effectiveness and safety. Healthcare providers should closely monitor the neonate's vital signs, including blood pressure, heart rate, and respiratory rate, to determine the patch's impact on the body.
Adjustments to the Clonidine dosage may be necessary based on the neonate's individual response and tolerance. Healthcare professionals should evaluate the patient's symptoms and overall condition regularly to assess the need for dose adjustments.
Monitoring and adjustment of the Clonidine patch therapy should be conducted under the guidance and supervision of a qualified healthcare provider to optimize the treatment benefits while minimizing the risk of side effects.
Safety Precautions
When using the Clonidine Patch, it is essential to follow safety precautions to ensure the well-being of neonates. Here are some important safety measures to keep in mind:
1. Always apply the patch as instructed by healthcare professionals to avoid improper dosing.
2. Keep the patch out of reach of children and pets to prevent accidental ingestion.
3. Do not use the patch if the packaging is damaged or if the patch is expired.
4. Monitor the neonate for any signs of skin irritation, allergic reactions, or adverse effects while using the patch.
5. Store the patches in a cool, dry place away from direct sunlight and heat sources.
6. In case of any unusual symptoms or concerns, consult a healthcare provider immediately.
7. Do not cut or alter the patch in any way, as this can affect its efficacy and safety.
By adhering to these safety precautions, you can help ensure the safe and effective use of the Clonidine Patch for neonates.
Potential Risks and Side Effects
While Clonidine patches can be effective in managing hypertension in neonates, there are potential risks and side effects that should be considered:
1. Hypotension:
One of the main concerns with using Clonidine in neonates is the risk of hypotension, which can lead to dizziness, fainting, or even shock. Monitoring blood pressure regularly is essential to prevent this complication.
2. Bradycardia:
Clonidine can also cause bradycardia, a condition characterized by a slow heart rate. This can be dangerous in neonates, as it may lead to inadequate blood flow to vital organs. Close monitoring of heart rate is crucial when using Clonidine patches.
Overall, while Clonidine patches can be beneficial in managing neonatal hypertension, healthcare providers should closely monitor for these potential risks and side effects to ensure the safety and well-being of the infant.
Interaction with Other Medications
When using Clonidine Patch in neonates, it is important to be aware of potential interactions with other medications. Always consult with a healthcare professional before combining Clonidine Patch with any other drugs.
Some medications that may interact with Clonidine Patch include:
- Antidepressants
- Blood pressure medications
- Beta-blockers
- Sedatives
- Alcohol
These are just a few examples, and there may be other medications that can interact with Clonidine Patch. It is important to disclose all medications, supplements, and herbal products you are taking to your healthcare provider to avoid any potential drug interactions.
Monitoring for any signs of adverse effects or changes in medication efficacy is crucial when combining Clonidine Patch with other medications. Always follow the guidance of your healthcare provider to ensure safe and effective use of Clonidine Patch in neonates.
